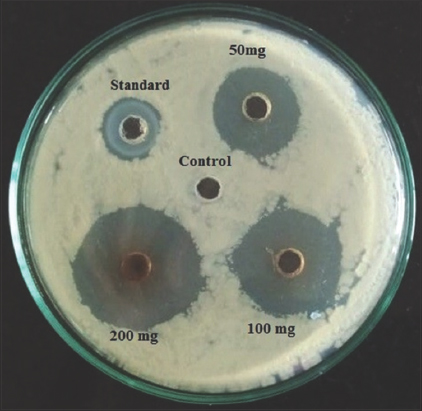

1. INTRODUCTION
Among the different production risks affecting Banana farming, Fusarium wilt is considered as the most important disease globally, particularly in the tropical and subtropical regions [1,2]. This disease is caused by Fusarium oxysporum f. sp. cubense (Foc). It was first noticed in Australia in 1874. The disease, now, has been reported from the most Banana growing regions [3]. In India, except Nendran and Red Banana, the disease is causing extensive damage in entire Banana cultivation areas particularly affecting nearly all commercial varieties [2,4].
Karnataka is well known for the production of prime quality Bananas specially “Nanjangud rasabale” (NRB) which has its origin from a place called “Nanjangud” in the Mysuru district. Due to its high nutritional content, good fibrous texture, excellent taste, color, and aroma, NRB is most popular and pricey fruit in Karnataka and also in other states. However, the Banana wilt is a big limitation for the profitable production of this elite variety [5].
Foc is a soil-residing filamentous fungus that mainly produces asexual reproductive structures called chlamydospores, micro and macroconidia which are produced on branched or unbranched monophialides [Figure 1]. This enables the fungus to survive for additional 30 years in the soil, even without related host [6].
 | Figure 1: Reproductive structures of Fusarium oxysporum f. sp. cubense. (a) Mycelium, (b) Macroconidia, (c) Chlamydospores, and (d) Microconidia. [Click here to view] |
Through the roots, fungus infects Banana plants and enters xylem (vascular tissue). Then, it blocks the transportation of water and minerals causing certain visible external symptoms such as progressive wilting, gradual yellowing of leaves which spread from outer leaf margins and extend to the middle and from older leaves to younger parts and finally collapsing at the petiole region and splitting of outer leaf tissues takes place longitudinally in the pseudostem of Banana plant [7,8]. The disease shows internal symptoms such as quintessential discoloration ranging from light yellow to dark brown color. It affects vascular tissue particularly in roots, rhizome, and pseudostem and also in the stalk of the fruit [9,10]. In the due course, the disease causes death of Banana plants [8] [Figure 2].
 | Figure 2: Symptoms of Fusarium wilt of Banana. (a) Plant showing Pseudostem splitting, (b) transversal cut of pseudostem showing an advanced necrosis of vascular tissues, (c) leaf falling by petiole collapse, (d) transversal section of rhizome showing tissue necrosis, and (e) general yellowing and necrosis of leaves (“yellow leaf syndrome”) in advance stage of disease. [Click here to view] |
Till date, no control methodology has been introduced to effectively manage the disease. Due to the soil borne nature of Fusarium and chlamydospores, it is hard to manage the disease [11]. Quarantine is the only best approach [12-14]. However, these practices could be applied largely in big plantations, not in small holder settings [15].
Keeping in picture of downsides of chemical fungicides using for the control of disease, the use of botanicals for developing management approaches is gaining more importance nowadays. Hence, in the current investigation, seven medicinal plant extracts were tested in vitro against the pathogen [16,17].
2. MATERIALS AND METHODS
2.1. Survey on Panama Disease
Period 2017–19, the survey was conducted at various places of Mysuru and Chamarajanagara districts. Type of soil, disease incidence, type of the planting material and cultivar used, and vascular infection of pseudo stem were recorded. Samples from each site were collected for the isolation of pathogen. Random samples were taken in each plot, total number of plants and number of plants affected were calculated as percent disease incidence [18].
 |
2.2. Pathogen Isolation from Plant Material
The wilt affected parts of Banana plant (rhizome, pseudostem) and soil were collected separately in a polythene bags and labeled. Infected material was sectioned into small pieces and were washed properly under tap water and surface sterilized with 0.1% sodium hypochlorite. The prepared plant pieces were plated on PDA (Hi Media) medium, incubated at 22±1°C for 7–15 days under 12/12 h under U V light and darkness.
The pathogen was identified based on the morphological characteristics. Pure culture was obtained and maintained for further studies [19] [Figure 3].
 | Figure 3: Fusarium oxysporum f. sp. cubense on PDA media. [Click here to view] |
2.3. Preparation of Plant Extracts
Seven medicinal plants [Table 1] were selected based on the earlier work conducted in the Center for Innovative Studies in Herbal Drug Technology, Department of studies in Botany and literature review. The plant materials were collected and washed under running tap water, dried, and then homogenized in to a coarse powder and preserved in sealed bottles. About 50 g of coarsely powdered plant material was subjected to Soxhlet extraction using methanol as a solvent. Extract was collected and dried using rotary evaporator and preserved for future studies [20].
Table 1: List of plants used in the study.
| Botanical name | Common name | Family | Part used |
|---|---|---|---|
| Piper betle | Betel | Piperaceae | Leaves |
| Prosopis juliflora | Algaroba | Mimosaceae | Leaves |
| Garcinia indica | Kokum | Clusiaceae | Dried Fruit rind |
| Callistemon lanceolatus | Bottle brush | Myrtaceae | Leaves |
| Azadirachta indica | Neem | Meliaceae | Leaves |
| Decalepis hamiltonii | Makali beru | Apocynaceae | Roots |
| Combretum indicum | Rangoon creeper | Combrataceae | Leaves |
2.4. Extract Preparation for Antifungal Assay
The samples were solubilized at different concentration (50 mg/ml, 100 mg/ml, and 200 mg/ml) in 20 % methanol and sonicated for 30 min. Dissolved samples were centrifuged [21].
2.5 Poisoned Food Technique
For poisoning food technique, PDA media was prepared, autoclaved, and poured into glass petri plates (10 ml/plate). Plant extract was added to PDA at concentration of 50 mg/ml, 100 mg/ml, and 200 mg/ml and allowed to solidify. Round disk of 6 mm from 7-day-old culture with grown mycelium was taken and was inoculated in center of media plate upside down. Chlorhexidine was used as a commercial standard and methanol is used as blank. After inoculation, plates were incubated at 30°C for 3–7 days [22,23]. Zone of inhibition (ZOI) was measured (in mm) and percentage of growth inhibition was determined using the formula:
 |
where, dc = Average increase in mycelial growth in control.
dt = Average increase in mycelial growth in treated media.
2.6. Agar-Well Diffusion Method
Test plates were prepared with 20 ml of PDA for well diffusion method. After media get solidified, 100 μL of Foc suspension of 0.5–2.5×103 concentration was added and uniformly spread over plates using L shaped rod. For well diffusion assay, wells (about 6mm diameter) were prepared and 40 μL with different concentration of the plant extract were added. 30 μL Chlorhexidine (200 μg/ml) was used as a commercial standard. 20% methanol was loaded as blank. A loading was completed, the plates were kept in aseptic conditions to allow the full absorption of plant extracts employed in the study. After that, plates were incubated at appropriate growth conditions for 24–48 h. After the period of incubation, plates were examined for the inhibition zone of fungal growth and measured in mm [24].
2.7. Disk Diffusion Method
Test plates were prepared with 20 ml of PDA for disk diffusion method. After media get solidified, 100 μL of Foc suspension of 0.5–2.5 × 103 was added and uniformly spread over plates using L shaped rod. Sterile disks were placed and loaded with 40 μL different concentration of the plant extract step by step with a time gap of 20 min for sample diffusion. 30 μL Chlorhexidine (200 μg/ml) was used as a commercial standard. 20% methanol was loaded as blank. once loading was complete, plates were kept in aseptic conditions to allow the complete absorption of plant extracts employed in the study. After that, the plates were incubated at appropriate growth conditions for 24–48 h. After the period of incubation, plates were examined for the inhibition zone of fungal growth encircling the well were measured in mm and recorded [24].
2.8. Minimum Inhibitory Concentration (MIC) Assay
The MIC was determined based on the broth dilution method using 96 well plates [25]. For the determination of MIC, inoculum suspension was prepared from broth cultures. Foc culture was adjusted to 0.5 McFarland turbidity standards (1.5 × 108 CFU/ml) and 10 μL of diluted suspensions of fungal culture was added to 50 μL of various concentrations of methanolic extract of Garcinia indica in to the well. The 40 μL of extract from 50 mg/ml stock was added in the three columns of first row. The extract was serially diluted from first row to last row. The sample concentration ranged from 20 mg/ml, 10 mg/ml, 5 mg/ml, 2.5 mg/ml, 1.25 mg/ml, 0.625 mg/ml, 0.3125 mg/ml, and 0.15625 mg/ml for samples from first to last row. 30 μL chlorhexidine from 200 μg/ml stock was added in the first row, 3 column of standard. The standard was serially diluted from the first to last row. The standard concentration ranged from 60 μg/ml, 30 μg/ml, 15 μg/ml, 7.5 μg/ml, 3.75 μg/ml, 1.875μg/ml, 0.9375 μg/ml, and 0.469 μg/ml. Sterile broth with 20% methanol served as a media blank and only Foc culture without treatment was considered as control. Plates were incubated at 25±2°C for 48 h. After incubation, optical density was taken at 600 nm to analyze the inhibition of Foc.
3. RESULTS
The survey data collected during 2017–2019 in the main Banana growing regions of Mysuru and Chamarajanagar are presented in Table 2. In Chamarajanagar district, the incidence of wilt disease was highest (95.4%) in Singanalluru, Kollegala (T) Chamarajanagar (D) followed by Duggahalli (90%) Nanjanagudu (T) Mysuru (D).
Table 2: Survey for incidence of Panama wilt of Banana.
| Place | Variety/cultivar | Soil type | Planting material used | Incidence of disease (%) | Pseudostem vascular infection | Stage of crop (Months) |
|---|---|---|---|---|---|---|
| Singanalluru | Ney Poovan (AB) (Yalakki bale) | Red loamy soil | Sucker | 95.4 | 5 | 6 |
| Near temple | Ney Poovan (AB) (Yalakki bale) | Red soil | Tissue cultured | 81.8 | 4 | 7 |
| Thumbala, | Ney Poovan (AB) (Yalakki bale) | Red soil | Tissue cultured | 16.6 | 4 | 7 |
| Mallupura, | Ney Poovan (AB) (Yalakki bale) | Red loamy soil | Sucker | 25 | 4 | 6 |
| Vatalpura | Ney Poovan (AB) (Yalakki bale) | Red loamy soil | Sucker | 22.2 | 5 | 10 |
| Alathur | Ney Poovan (AB) (Yalakki bale) | Red loamy soil | Sucker | 10 | 3 | 8 |
| Pillahalli, | Rasthali (AAB) (Rasabale) | Red loamy soil | Tissue cultured | 28 | 3 | 6 |
| Basavanapura | Ney Poovan (AB) (Yalakki bale) | Black soil | Sucker | 10 | 2 | 5 |
| Duggahalli (Plot 1) Nanjanagudu | Ney Poovan (AB) (Yalakki bale) | Red loamy soil | Sucker | 36.6 | 4 | 7 |
| Duggahalli (Plot 2) Nanjanagudu | Ney Poovan (AB) (Yalakki bale) | Red loamy soil | Sucker | 90 | 6 | 10 |
Pseudostem Vascular Infection Scaled range from 1 to 6, 0: No disease, 1: Corm completely clean, no vascular discoloration, 2: Isolated points of discoloration in vascular tissue, 3: Discoloration up to 1/3rd of vascular tissue, 4: Discoloration of between 1/3rd and 2/3rd of vascular tissue, 5: Discoloration greater than 2/3rd of vascular tissue, 6: Total Discoloration of vascular tissue
Results of poisoned food technique for determining antifungal efficacy of seven methanolic plant extracts against Panama wilt pathogen are shown in Table 3. All the seven plant extracts showed inhibition of Foc in vitro with different percentage.
Table 3: Poison food technique showing antifungal activity.
| Samples | ZOI (cm) | % of inhibition | ZOI (mm) of sample 2 mg/ml | % of inhibition 2 mg/m | ZOI (mm) of sample 4 mg/ml | % of inhibition 4 mg/ml | ZOI (mm) of sample 8 mg/ml | % of inhibition 8 mg/ml |
|---|---|---|---|---|---|---|---|---|
| Azadirachta indica | - | - | 60 | 14.2 | 60 | 14.2 | 58 | 17 |
| Piper betle | - | - | 48 | 31.4 | 31 | 55.7 | 30 | 57 |
| Callistemon lanceolatus | - | - | 64 | 8.5 | 64 | 8.5 | 58 | 17 |
| Prosopis juliflora | - | - | 49 | 30 | 41 | 41 | 34 | 51 |
| Combretum indicum | - | - | 58 | 17 | 52 | 25.7 | 49 | 30 |
| Garcinia indica | - | - | 48 | 31 | 45 | 35.7 | 20 | 71 |
| Decalepis hamiltonii | - | - | 58 | 17 | 55 | 21 | 53 | 24 |
| Control | 7 | - | - | - | - | - | - | - |
| MeoH (40 mL/mL) | 6.7 | 4 | - | - | - | - | - | - |
| Standard (30 mL/mL) | 2.8 | 60 | - | - | - | - | - | - |
ZOI: Zone of inhibition; Bold value: Plant extract showing significant activity
Among all the different treatments used, results showed that highest inhibition, that is, 71% was recorded in 200 mg/ml methanolic plant extract of G. indica (20 mm) [Figure 4]. About 57% were recorded in 200 mg/ml methanolic extract of Piper betle which showed 30 mm ZOI. The least inhibition was observed in Callistemon lanceolatus (17%). Moderate inhibition was observed in methanolic extracts of Prosopis juliflora (51%), Combretum indicum (30%), and Decalepis hamiltonii (24%) [Figure 5].
 | Figure 4: Poison food technique showing antifungal activity of Garcinia indica against Foc. [Click here to view] |
 | Figure 5: Percentage of inhibition in poison food technique. [Click here to view] |
Results of disk diffusion method showing antifungal efficacy of seven methanolic plant extracts against Banana wilt pathogen are presented in Table 4. Among seven extracts employed for the study, G. indica exhibited significant antifungal activity against Foc with the maximum ZOI of 29 mm at the concentration of 200 mg/ml [Figure 6]. Other two concentrations of G. indica also showed good efficacy against Foc with the ZOI 25 mm and 18 mm at the concentration of 100 mg/ml and 50 mg/ml, respectively. P. betle methanolic extract also demonstrated good results against Banana wilt pathogen with the ZOI of 21 mm at the concentration of 200 mg/ml [Figure 7].
Table 4: ZOI of samples against Fusarium oxysporum f. sp. cubense using Disk diffusion.
| Samples | *ZOI (mm) of Standard (6 mg/well) | ZOI (mm) of sample 50 mg/ml | ZOI (mm) of sample 100 mg/ml | ZOI (mm) of sample 200 mg/ml |
|---|---|---|---|---|
| Azadirachta indica | 15 | 0 | 0 | 10 |
| Piper betle | 15 | 11 | 15 | 20 |
| Callistemon lanceolatus | 16 | 11 | 17 | 21 |
| Prosopis juliflora | 17 | 19 | 20 | 21 |
| Combretum indicum | 17 | 15 | 17 | 20 |
| Garcinia indica | 17 | 18 | 25 | 29 |
| Decalepis hamiltonii | 16 | 0 | 0 | 0 |
* ZOI: Zone of Inhibition
 | Figure 6: Zone of inhibition of Garcinia indica using disk diffusion method. [Click here to view] |
 | Figure 7: Zone of inhibition in disk diffusion method. [Click here to view] |
Results of agar-well diffusion method for seven methanolic plant extracts against Banana wilt pathogen are tabulated in Table 5. Figure 8 shows the inhibition zone diameters for G. indica which showed the maximum efficacy against Foc with the ZOI of 29 mm at the concentration of 200 mg/ml, this is followed by P. betle which showed the ZOI 25 mm at 200 mg/ml concentration [Figure 9].
Table 5: ZOI of samples against Fusarium oxysporum f. sp. cubens using well diffusion.
| Samples | ZOI (mm) of Standard (6 mg/well) | ZOI (mm) of sample 50 mg/ml | ZOI (mm) of sample 100 mg/ml | ZOI (mm) of sample 200 mg/ml |
|---|---|---|---|---|
| Azadirachta indica | 15 | 0 | 09 | 1 |
| Piper betle | 15 | 16 | 21 | 25 |
| Callistemon lanceolatus | 17 | 14 | 18 | 23 |
| Prosopis juliflora | 16 | 18 | 19 | 22 |
| Combretum indicum | 14 | 13 | 14 | 16 |
| Garcinia indica | 15 | 21 | 26 | 29 |
| Decalepis hamiltonii | 16 | 0 | 0 | 0 |
ZOI: Zone of inhibition; Bold value: Plant extract showing significant activity
| Figure 8: Zone of inhibition of Garcinia indica using well diffusion method. [Click here to view] |
 | Figure 9: Zone of inhibition in well diffusion method. [Click here to view] |
In the present study, it was found that the methanolic extract of fruit rind of G. indica at all the concentrations in all the three methods showed significant antifungal activity against Banana wilt pathogen – Foc. Hence, G. indica was used for MIC assay.
The MIC is defined as the lowest concentration that inhibited the fungal growth to an absorbance lower than 0.05 at 600 nm. The MIC of the methanol extract of fruit rind of G. indica was found to be at 0.625 mg/ml.
4. DISCUSSION AND CONCLUSION
Banana is one of the main food and fruit worldwide. Fusarium wilt is increasingly threatening the Banana production. Traditional methods like chemical control of Foc are employed, but they are not adequate to control the disease. Besides, the methods are hazardous to environment [26]. Therefore, the environment friendly approaches are required to control the wilt pathogen [27].
The hunt for antifungals from natural sources like plant has gained much importance nowadays and attempts have been put into point out compound in plants that can act as convenient antifungal agent to replace the chemical pesticides. Phytochemicals procured from plant products set out as an example to evolve less harmful or nontoxic and more efficient medicine for managing the growth of microorganism [28,29].
In the present work, antifungal efficacy of seven plant extracts was tested against the wilt fungus. It is noticeable that, all the seven methanolic extracts of plants are efficient in inhibiting the growth of mycelia of Foc.
Results of the present study depict that G. indica fruit rind extract showed very good antifungal effect in minimum concentration in comparison with the commercial standard used in all the three techniques employed in the study. P. betle also showed good efficacy against the pathogen by showing inhibition of Foc in vitro. These results are in accordance with the study of Gnanashekaran et al., [29] who tested five plants against Foc, among them, P. betle plant extract exhibited maximum antifungal activity.
In the study of Mengane and Kamble [16], Azadirachta indica showed maximum inhibition of the wilt pathogen followed by Eucalyptus and Artessemia. In our work, Azadirachta also showed inhibition of Foc. Ul Qurat and Shahzad [30], work using some Gymnospermic cone extracts against Banana wilt fungus, showed up to 70% inhibition of the test fungus. Kubara et al. [31], found that Acacia nilotica leaves extracts are good in inhibiting the pathogen. Among the three plant extracts examined at the concentration of 75%, 50%, and 25% plant extracts suppressed the disease in seedlings with the survival rate of 50%, 49%, and 48%.
From the current work and review of literature, we can find that plants can be excellent source of phytochemicals and would definitely yield better antifungal products that could be more friendly with environment and can be biodegradable.
From the results of present study, it is concluded that the fruit rind extract of G. indica is effective against panama wilt pathogen Foc. Further, isolation and characterization of bio active compounds in the extract and field experiments are to be carried out to recommend the herbal remedy against the Banana wilt.
5. ACKNOWLEDGMENT
The authors wish to extent their heartfelt gratitude to Dr. K.A. Raveesha for providing guidance, support, and sharing his expertise.
6. AUTHORS’ CONTRIBUTIONS
All authors made substantial contributions to conception and design, acquisition of data, or analysis and interpretation of data; took part in drafting the article or revising it critically for important intellectual content; agreed to submit to the current journal; gave final approval of the version to be published; and agree to be accountable for all aspects of the work. All the authors are eligible to be an author as per the international committee of medical journal editors (ICMJE) requirements/guidelines.
7. FUNDING
There is no funding to report.
8. CONFLICTS OF INTEREST
The authors report no financial or any other conflicts of interest in this work.
9. ETHICAL APPROVALS
This study does not involve experiments on animals or human subjects.
10. DATA AVAILABILITY
All data generated and analyzed are included within this research article.
11. PUBLISHER’S NOTE
This journal remains neutral with regard to jurisdictional claims in published institutional affiliation.
REFERENCES
1. Ploetz RC, Thomas JE Slaubaugh E. Diseases of banana and plantain. In:Ploetz RC, editors. Diseases of Tropical Fruit Crops. Wallingford, Oxon, UK:CABI Publishing;2003. 73-134. [CrossRef]
2. Thangavelu R, Gopi M. Field suppression of Fusarium wilt disease in banana by the combined application of native endophytic and rhizospheric bacterial isolates possessing multiple functions. Phytopathol Mediterr 2015;54:241-52.
3. Moore NY, Bentley S, Pegg KG, Jones DR. Fusarium wilt of Banana. Australia:Musa Disease Fact Sheet No. 5;1995.
4. Thangavelu R, Mustaffa MM. First report on the occurrence of a virulent strain of Fusarium wilt pathogen (Race 1) infecting Cavendish (AAA) group of Bananas in India. Plant Dis 2010;94:1379. [CrossRef]
5. Somu R, Thammaiah N, Swamy GS, Kulkarni MS, Devappa V. In vitro Evaluation of fungicides against Fusarium oxysporum f. sp. cubense. Int J Plant Prot 2014;7:22124.
6. Nel B. Management of Fusarium wilt of Banana by Means of Biological and chemical Control and Induced Resistance. Ph.D Thesis, University of Pretoria;2004.
7. Yin XM, Jin ZQ, Xu BY, Ma WH, Fu YG, Wang JB. Characterization of early events in Banana root infected with the GFP-tagged Fusarium oxysporum f.sp. cubense. Acta Hortic 2011;897:371-6. [CrossRef]
8. Guo G, Wang B, Weihong M, Xiaofen L, Yang X, Zhu C, et al. Biocontrol of Fusarium wilt of Banana:Key influence factors and strategies. Afr J Microbiol Res 2013;7:4835-43. [CrossRef]
9. Ploetz RC. Fusarium wilt of Banana is caused by several pathogens referred to as Fusarium oxysporum f sp. cubense. Phytopathology 2006;96:653-6. [CrossRef]
10. Minerdi D, Moretti M, Gilardi G, Barberio C, Gullino ML, Garibaldi A. Bacterial ectosymbionts and virulence silencing in a Fusarium oxysporum strain. Environ Microbiol 2008;10:1725-41. [CrossRef]
11. Booth C. The Genus Fusarium. Kew, Surrey:Common Wealth Mycological Institute;1971. 237.
12. Stover RH. Fusarial Wilt (Panama Disease) of Bananas and other Musa Species. Kew, Surrey:Common Wealth Mycological Institute;1962. 117.
13. Ploetz RC. Fusarium wilt of Banana. St. Paul, Minnesota, USA:APS Press;1990.
14. Ploetz RC. Panama disease:Return of the first Banana menace. Int J Pest Manag 1994;40:326-36. [CrossRef]
15. Maryani N, Lombard L, Poerba YS, Subandiyah S, Crous PW, Kema GH. Phylogeny and genetic diversity of the Banana Fusarium wilt pathogen Fusarium oxysporum f.sp. cubense in the Indonesian centre of origin. Stud Mycol 2019;92:155-94. [CrossRef]
16. Mengane SK, Kamble SS. Bioefficacy of plant extracts on Fusarium oxysporum f.sp. cubense causing panama wilt of Banana. Int J Pharm Biol Sci 2014;4:24-7.
17. Harish S, Kavino M, Kumar N, Balasubramanian P, Samiyappan R. Induction of defense related proteins by mixture of plant growth promoting endophytic bacteria against Banana bunchy top virus. Boil Control 2009;51:16-25. [CrossRef]
18. Somu R, Thammaiah N, Kulkarni MS, Swamy GS, Devappa V. Roving survey on Panama disease (Fusarium oxysporum f. sp. cubense) in Banana growing areas of Karnataka. Int J Plant Protect 2013;6:56-58.
19. Pérez VL, Dita MA, Martínez-de La PE. Technical manual prevention and diagnostic of Fusarium wilt (Panama disease) of Banana caused by Fusarium oxysporum f. sp. cubense tropical race 4 (TR4). Food Agric Organ Unit Nations 2014;4:1-74.
20. Satish S, Mohana DC, Raghavendra MP and Raveesha KA. Antifungal activity of some plant extracts against important seed borne pathogens of Aspergillus sp. J Agric Technol 2007;3:109-19.
21. Nene YL, Thapliyal PN. Fungicide in Plant Disease Control. 3rd ed. New Delhi:Oxford and IBH publishing Co. Pvt. Ltd, New Delhi;1973. 235.
22. Mohana DC, Raveesha KA. Antifungal evaluation of some plant extracts against some plant pathogenic field and storage fungi. J Agric Technol 2007;4;119-37.
23. Bauer AW, Perry DM, Kirby WM. Single disc antibiotic sensitivity testing of staphylococci and analysis of techniques and results. AMA Arch Intern Med 1956;104:208-16. [CrossRef]
24. National Committee for Clinical Laboratory Standards. Reference Method for Broth Dilution Antifungal Susceptibility Testing of Yeasts. Pennsylvania:Pro-Posed Standard M27-P. Villanova, PA:National Committee for Clinical Laboratory Stan-Dards;1992.
25. Siamak SB, Zheng S. Banana Fusarium wilt (Fusarium oxysporum f. sp. cubense) control and resistance, in the Context of developing wilt-resistant Bananas within sustainable production systems. Hortic Plant J 2018;4:208-18. [CrossRef]
26. Babar KZ, Shahzad A, Javed NA, Abdul J, Wasi UD, Rana MA. Antagonistic potential of Trichoderma harzianum against Fusarium oxysporum f. sp. cubense associated with panama wilt of Banana. Pak J Phytopathol 2007;29:111-6.
27. Durgeshlal C, Khan MS, Prabhat SA, Prasad YA. Antifungal activity of three different ethanolic extract against isolates from diseased rice plant. J Anal Tech Res 2019;1:47-63. [CrossRef]
28. Zaker M. Natural plant products as eco-friendly fungicides for plant disease control. A Sci J Krishi Found 2016;14:134-41. [CrossRef]
29. Gnanashekaran P, Mohamed S, Panneerselvam A, Umamagheswari. In vitro biological control of Fusarium oxysporum f. sp. cubense by using some Indian medicinal plants. Int J Curr Res Acad Rev 2015;3:107-16.
30. Ul Qurat A, Shahzad A. Antifungal potential of gymnospermic cones against panama wilt fungus (Fusarium oxysporum f. sp. cubense). J Biodivers Environ Sci 2017;10:138-47.
31. Kubara AK, Omoniyi AM, Olayiwola AH. Antifungal efficacy of three plant extracts in the suppression of panama disease in Banana plants. GSC Biol Pharm Sci 2018;5:95-103. [CrossRef]